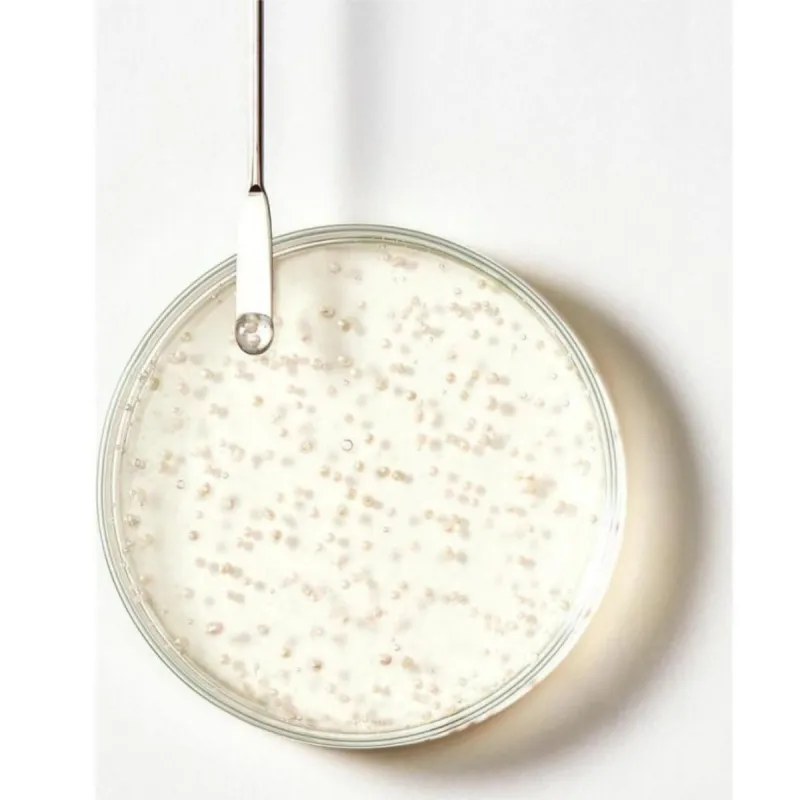
Furterer Triphasic Shampoing 200ml + 25% OFFERT Furterer Triphasic Shampoing 200ml + 25% OFFERT

Furterer Triphasic Shampoing 200ml + 25% OFFERT
Furterer Triphasic Shampoing est le shampooing complémentaire des soins traitants anti-chute Triphasic.
Livraison Gratuite
Livraison en point relais offerte dès 39€ d'achats
Livraison en point relais offerte dès 39€ d'achats
Conseils et commandes
Notre service client est disponible de 9h à 12h par téléphone afin de vous aider dans votre commande au 04 98 13 03 88
Besoin d'aide ? Appelez-nous au 04 98 13 03 88
Produits expédiés en 24h
Tous vos produits sont expédiés en 24h ouvrées depuis nos locaux situés dans le sud de la France afin de vous garantir une livraison la plus rapide possible.
Tous vos produits sont expédiés en 24h ouvrées
Cadeau
Pour nos plus belles commandes, on glisse dans vos colis des petits cadeaux
Un cadeau à partir de 99€ d'achats
Le shampoing Furterer Triphasic un shampooing qui cible la chute des cheveux.
Quels sont les actifs du Shampooing Antichute Triphasic de Furterer ?
- biosphères d'huiles essentielles sont des capsules infusées d'huiles essentielles qui se brisent lors de l'application, libérant des nutriments qui stimulent le cuir chevelu. Ces huiles essentielles sont souvent utilisées pour améliorer la circulation sanguine du cuir chevelu, ce qui peut contribuer à une meilleure croissance des cheveux,
- extrait de Pfaffia Bio (ou Ginseng brésilien) est connue pour ses propriétés stimulantes et fortifiantes, cette plante aide à revitaliser le cuir chevelu et à nourrir les follicules pileux, créant un environnement propice à la croissance des cheveux,
- extrait de Ginseng, traditionnellement utilisé dans les soins capillaires pour ses effets revitalisants, le ginseng aide à renforcer les racines des cheveux et à stimuler leur croissance.
Pourquoi utiliser le Shampooing Antichute Triphasic de Furterer ?
- réduction de la chute des cheveux grâce aux ingrédients actifs aident à ancrer le cheveu plus fermement dans le cuir chevelu, réduisant ainsi la chute des cheveux due à la casse.
- cheveux plus denses et forts, en stimulant le cuir chevelu et en nourrissant les follicules, ce shampoing peut aider à améliorer la densité et la texture des cheveux, les rendant visiblement plus épais et plus forts,
- hydratation et brillance grâce aux composants hydratants du shampoing assurent que les cheveux ne se dessèchent pas, les laissant doux et brillants.
Le Shampoing Antichute Furterer Triphasic est un excellent choix pour combattre la chute des cheveux et promouvoir une croissance saine. Grâce à ses ingrédients naturels et à sa formule stimulante, il offre une approche globale pour maintenir la santé des cheveux et du cuir chevelu.
Sans silicone, sans tensio-actifs sulfatés.
Conseils d'utilisation du Shampooing Antichute Triphasic de Furterer :
Appliquez sur cheveux mouillés, massez par mouvements circulaires de la nuque jusqu'au sommet du crâne, rincez.
Bon résultats , bonne qualité et bonne marque
| Marque | Furterer |
|---|---|
| Référence | 3282770389999 |
| Contenance | 0.276 |
Water (Aqua), Sodium Myristoyl Glutamate, Sodium Laureth Sulfate, Inulin, Decyl Glucoside, Alcohol (Alcohol Denat), Propanediol, Acrylates/C10-30 Alkyl Acrylate Crosspolymer, PEG-40 Hydrogenated Castor Oil, Agar, Algin, Calcium Aluminium Borosilicate, Citral, Citric Acid, Aurantium Dulcis (Orange) Oil (Citrus Aurantium Dulcis Oil), Disodium Adenosine Triphosphate, Fragrance (Parfum), Glycerin, Hexyl Cinnamal, Lauryl Betaine, Lavandula Angustifolia (Lavender) Oil (Lavandula Angustifolia Oil), Lavandula Hybrida Oil, Linalool, Mica, PEG-30 Dipolhydroxystearate, PEG-4, Pfaffia Paniculata Root Extract, Phenoxyethanol, Polyquaternium-39, Polysorbate 20, Rosmarinus Officinalis (Rosemary) Leaf Oil (Rosmarinus Officinalis Leaf Oil), Silica, Sodium Benzoate, Sodium Chloride, Tin Oxide, Titanium Dioxide (CI77891), Tocopheryl Acetate, Trideceth-6.